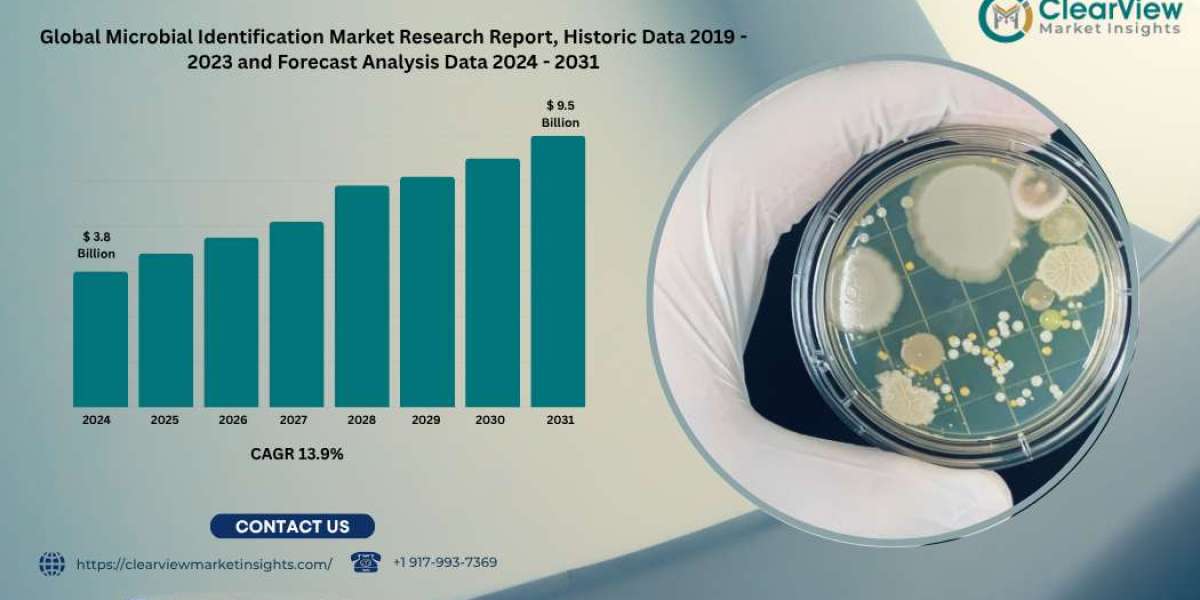
Article Picture

The Global Drug-Resistant Tuberculosis Treatment Market size is expected to be worth around USD 1,802.4 Million by 2033 from USD 1,117.1 Million in 2023, growing at a CAGR of 4.9% during the forecast period from 2024 to 2033.
The Drug-Resistant Tuberculosis Treatment Market is evolving in 2025 with the emergence of long-acting injectables and precision diagnostics that are reshaping therapeutic strategies. Injectable formulations with sustained drug release are being tested to maintain therapeutic levels over weeks, reducing pill burden and improving adherence. Simultaneously, novel molecular diagnostics—such as rapid PCR assays and whole-genome sequencing—are enabling clinicians to detect resistance profiles at diagnosis, ensuring patients receive the most effective medications quickly.
These advances help eliminate trial-and-error prescribing while mitigating the development of further resistance. As integrated clinics pilot combined diagnostic and injectable pathways, initial results show improved cure rates and sharply reduced default rates. This challenge-response model is poised to redefine global DR-TB care—linking precision diagnosis with patient-friendly therapy.
Click here for more information: https://market.us/report/drug-resistant-tuberculosis-treatment-market/
Key Market Segments
Drug Class
- Amoxicillin/Clavulanate
- Bedaquiline
- Carbapenems with Clavulanic Acid
- Clofazimine
- Other Drug Classes
Disease Type
- Active TB
- Latent TB
Treatment Type
- First-Line Anti-TB Drugs
- Second-Line Anti-TB Drugs
Distribution Channel
- Hospital Pharmacies
- Online Pharmacies
- Retail Pharmacies
Key Takeaways
- Market Size: Drug-Resistant Tuberculosis Treatment Market size is expected to be worth around USD 1,802.4 Million by 2033 from USD 1,117.1 Million in 2023.
- Market Growth: The market growing at a CAGR of 4.9% during the forecast period from 2024 to 2033.
- Drug Class Analysis: Amoxicillin/Clavulanate stands out as the frontrunner among them, holding 35% market share.
- Disease Type Analysis: Active TB, which represents its contagious form, holds 55% market share.
- Treatment Type Analysis: First-Line Anti-TB Drugs have proven incredibly popular over time – they hold nearly 48% share.
- Distribution Channel Analysis: Hospital Pharmacies play a pivotal role, accounting for 42% of market share in 2023.
- Regional Analysis: North America holds the largest market share for Drug-Resistant Tuberculosis Treatment market revenue at 37% in 2023 and generated USD 413.3 Million.
Emerging Trends
- Monthly or biweekly long-acting injectables under clinical study.
- Rapid molecular resistance profiling at point-of-care.
- Precision treatment protocols based on genetic resistance maps.
- Combination clinic models delivering diagnostics and injectables during single visits.
Use Cases
- A DR-TB patient receives an injectable every 14 days instead of daily pills.
- PCR test on site guides customized regimen within 24 hours.
- Clinic pairs diagnosis and first injection in same appointment.
- Avoided drug switches due to instant identification of resistance mutations.